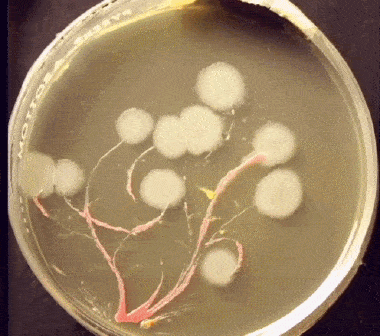
糕点蛋糕抽检菌落总数总是超标的原因分析和如何解决超标_奥克泰士
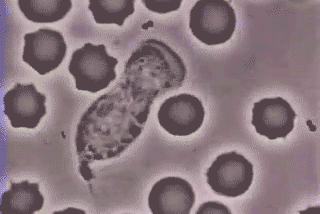
齐鲁早报|德州小伙儿捐献新冠恢复期血浆,为全省第一例|疫情|新冠肺炎

细菌动图

科普文章详情
图片尺寸400x280
臭脚有它不尴尬,每天喷一喷,3秒速干,5秒除臭,鞋子一天都不臭,吃饭脱
图片尺寸491x262
研究揭示了细菌细胞器如何组装-掌上离心机_迷你离心机_小型微型微量
图片尺寸480x270
李佳琦1分钟爆卖30万双!这双巨火的"踩屎感"拖鞋,防污防滑不臭脚,穿上
图片尺寸278x315
糕点蛋糕抽检菌落总数总是超标的原因分析和如何解决超标_奥克泰士
图片尺寸380x336
茵蕊小课堂 | 雨天不注意,得了妇科病?这些私护常识你不可不知
图片尺寸364x265
明明刷过牙,为什么还总是口臭?_口腔
图片尺寸639x456
最终,还是吃货支配了世界!_腾讯新闻
图片尺寸408x230
齐鲁早报|德州小伙儿捐献新冠恢复期血浆,为全省第一例|疫情|新冠肺炎
图片尺寸320x214
能吃的"果汁"牙膏,纽约时报,环球时报力荐_凤凰网
图片尺寸1075x503
99%的人洗菜方法都错了!10分钟洗掉农药,蜡质,寄生虫,就靠它!
图片尺寸279x208
口臭,屁臭,易长痘?严肃点,别哈哈哈不当回事..._肠道
图片尺寸287x161
季节交替,当心肠胃也会感冒_肠道
图片尺寸640x355
【好恶心】比电梯脏2倍,比公共厕所脏4倍!这东西你还敢碰么?!_细菌
图片尺寸475x265
安全又强效!用"乐活"绿色清洁粉,全家焕然一新_油渍
图片尺寸640x291
秋季腹泻来袭,宝宝上吐下泻时做好这几点,好的快!|上吐下泻|婴幼儿|腹
图片尺寸580x580
耐!药!君!是怎样炼成的?
图片尺寸640x1008
博士养群细菌当"宠物"玩赚了6000万_手机搜狐网
图片尺寸640x480
鞋臭好尴尬!用它喷一喷,除臭,杀菌二合一,明星也在用!_腾讯新闻
图片尺寸406x228
洗澡时多搓搓这2处,疏通全身,更显年轻,体味淡多了_皮肤
图片尺寸624x450